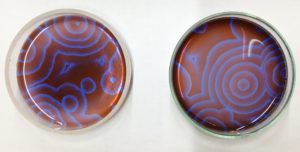

東京都高等学校理科研究発表会 審査員特別賞受賞!
- クラブ・委員会活動
- クラブ・委員会活動

11月24日(月)に行われた「第14回 東京都高等学校理科研究発表会」で、本校理化部の生徒が審査員特別賞を受賞しました。
Belousov-Zhabotinsky反応(ベロウゾフ-ジャボチンスキー反応、以下BZ反応)という反応について研究している高等部生4名が、ポスター発表を行いました。BZ反応とは、マロン酸などの有機酸が臭素酸イオンによって徐々に酸化される反応です。この一連の反応中で有色の鉄を中心とした錯イオンが酸化・還元反応を繰り返すため、図のような変色を伴う振動反応が生じます。
本研究では様々な反応条件(硫酸の添加量、温度)が与える影響や、素反応について調べています。今回は、その研究成果についての発表を行いました。

今後とも理化部の活動へのご支援をよろしくお願いいたします。
理化部顧問